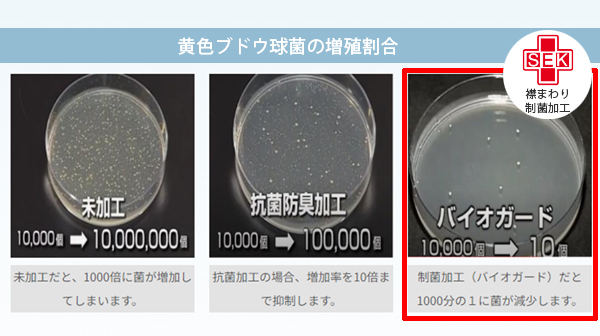

RSシャンプーケープ 制菌プラスRSシャンプーケープ
RSシャンプーケープ 制菌プラスRSシャンプーケープ
首回りに洗濯耐久性のある制菌加工の多機能素材を使用。特定の菌(※)の増殖を抑制かつ消臭加工により嫌な臭いの原因となるアンモニアや硫化水素に対して効果を発揮するため、とても衛生的です。
※黄色ブドウ球菌、肺炎桿菌、MRSA(メチシリン耐性黄色ブドウ球菌)など
¥4,400~
※ブラック ドロッパー付は¥4,900
- 品番
- EA-RSC
- 寸法
- 102(長)×95(幅)×58cm(後丈) 50cm(首回り)
※縫製品のため、+2センチ程度の誤差があります。
特長
-

制菌性と消臭性
首回りに洗濯耐久性のある制菌加工の多機能素材を使用。特定の菌(※)の増殖を抑制かつ消臭加工により4大悪臭といわれるアンモニアや硫化水素を中和無臭化するためとても衛生的です。
※黄色ブドウ球菌、肺炎桿菌、MRSA(メチシリン耐性黄色ブドウ球菌)など -
-

完全防水
素材は完全防水です。
仕様(スペック)
-

【材質】
ナイロン、メッシュトリコット、ウレタンラミネート、ラッカーコーティング(ドロッパー部分)
※サイズについて、縫製品のため+2センチ程度の誤差があります。
価格
| カラー | 品番 | 価格 |
|---|---|---|
| ホワイト | EA-RSCW2 |
¥4,400 |
| オレンジ | EA-RSCO2 |
¥4,400 |
| ブラック ドロッパー付き | EA-RSCBD2 |
¥4,900 |
TB WEB ORDERにてご購入いただけます。




